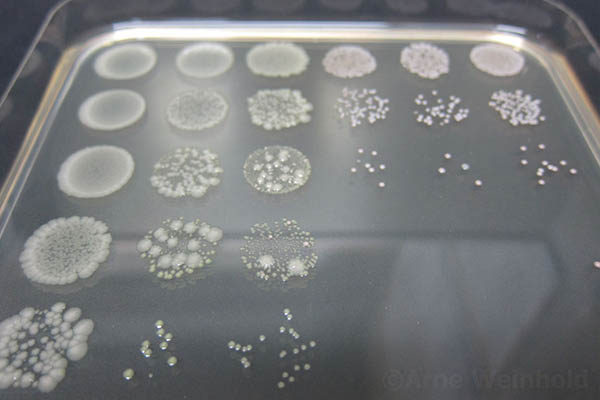
Adult Butterfly Microbes

Past Projects

Microbiome Function
My past research explored the functional roles of microbiomes in plants and insects. I used experimental manipulations and molecular tools to understand the impact of microbiome disturbances in both laboratory and field settings.
Functional Ecology of the Butterfly Microbiota
At Freie Universität Berlin I moved my research focus to the next trophic level on Insect-Microbe-Symbiosis. We investigated the functional ecology of the Adult Butterfly Microbiota using the cabbage white (Pieris brassicae) and found an parental effect on offspring performance (see Parental Legacy story). Such a trans-generational influence was unexpected but highlights the ecological significance of microbial acquisition for adult butterflies in natural environments.
Plant Microbiome Function
Past Research Interests
- Plant Microbiome Function
- Plant-Herbivore Interactions
- Agricultural Biotechnology
Parental Legacy of the Butterfly Microbiota

At the Collaborative Research Centre (CRC 973) at Freie Universität Berlin, the research focus was on the role of the egg-asociated microbiota of of Pieris brassicae on plant defense priming. I used mainly quantitative approaches and host manipulations to investigate the adult butterfly microbiota, which resulted in two important discoveries:
- Quantity: Adult butterflies harbor significantly higher bacterial loads compared to their larvae or eggs.
- Function: Parental microbiota affects offspring performance when larvae experience a host plant shift.






Plant Microbiome Manipulation



How to manipulate a plant’s microbiome under real-world conditions? At the Max Planck Institute for Chemical Ecology, I used an in-planta Microbiome Manipulation approach with transgenic plants. The goal was to test Microbiome Function—and its role in plant defense against herbivores—directly within a plants’ natural habitat. Among the ten different antimicrobial peptides (AMPs) tested, only a few proved to be viable candidates. However, the native endophytic bacteria displayed highly variable susceptibility to the expressed peptide, resulting in a Resilient Microbiome under field conditions. This highlights the importance of field research, as lab-based assays alone cannot capture the diversity of natural microbial communities.
In order to manipulate the microbiome, we used the expression of antimicrobial peptides. Our plants showed activity against different Bacillus species, which are mainly known as plant beneficial microbes. We assumed that that these transgenic plants might show deficits in growth or reproduction in field experiments. In other words: we wanted to make an unhappy plant to see how important microbes are for them. To our surprise, the plants appeared rather unimpressed when we compared them with controls in the field.






Feasting Foto Model
This photo of Manduca sexta from a glasshouse herbivore assay became a top ten 🏅 finalist in the 2022 pflanzenforschung.de photo contest.
Applying SynCom for Biocontrol



In one of our largest field trials we tested the application of a SynCom (synthetic bacterial community) as biocontrol agent on more than 735 plants. The continues cropping of Nicotiana attenuata on the research field plot resulted in the buildup of soil borne pathogens, similar as observed in agricultural fields. Plants were suddenly dying and showed black root symptoms. We tested different strategies including fungicide application and soil amendment. The use of biochar seemed like a natural choice, as young tobacco plants germinate after wildfires on burned soil. But none of these applications helped.
The best reduction in plant mortality could be achieved via inoculation with a SynCom of five bacterial strains. While individual inoculations where not as effective, the combination of all strains showed synergistic effects. These experiments highlight the importance of an early establishment of a microbial partnership with plants.
So far, only individual bacterial strains had been applied in agriculture. However, bacteria do not live alone, they form communities which complement each other. Only when they interact with each other they can exert their positive effects on plant health.




Saying that plants need “healthy soil” has a deeper meaning than we had been aware of until now. It simply means that a balanced microbial soil community is vital for plants to grow and remain healthy...
says Arne Weinhold (source MPG Research News)


Gleichgewicht des Mikroversums
Being recognized in science is always great. Our PNAS article was featured as an example for functional microbiome research in Jena when the Cluster of Excellence Balance of the Microverse was founded. Go Jena! Advancing microbial research!
More Information: Brakhage 2019 Biospektrum